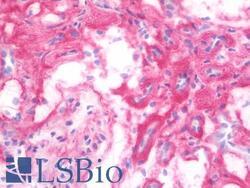

Antibody data
- Antibody Data
- Antigen structure
- References [0]
- Comments [0]
- Validations
- Immunohistochemistry [7]
Submit
Validation data
Reference
Comment
Report error
- Product number
- LS-B10057 - Provider product page

- Provider
- LSBio
- Product name
- IHC-plus™ HSPG2 / Perlecan Antibody (clone A7L6) LS-B10057
- Antibody type
- Monoclonal
- Description
- Protein G purified
- Reactivity
- Human, Mouse, Rat, Bovine
- Host
- Rat
- Isotype
- IgG
- Antibody clone number
- A7L6
- Storage
- Short term: store at 4°C. Long term: aliquot and store at -20°C. Avoid freeze-thaw cycles. Store undiluted.
No comments: Submit comment
Supportive validation
- Submitted by
- LSBio (provider)
- Enhanced method
- Genetic validation
- Main image

- Experimental details
- IHC with HSPG2 antibody on frozen human heart.
- Submitted by
- LSBio (provider)
- Enhanced method
- Genetic validation
- Main image

- Experimental details
- IHC with HSPG2 antibody on frozen human kidney.
- Submitted by
- LSBio (provider)
- Enhanced method
- Genetic validation
- Main image

- Experimental details
- IHC with HSPG2 antibody on frozen human spleen.
- Submitted by
- LSBio (provider)
- Enhanced method
- Genetic validation
- Main image
- Experimental details
- IHC with HSPG2 antibody on frozen human kidney.
- Submitted by
- LSBio (provider)
- Enhanced method
- Genetic validation
- Main image

- Experimental details
- IHC with HSPG2 antibody on frozen human heart.
- Submitted by
- LSBio (provider)
- Enhanced method
- Genetic validation
- Main image

- Experimental details
- IHC with HSPG2 antibody on frozen human kidney.
- Submitted by
- LSBio (provider)
- Enhanced method
- Genetic validation
- Main image

- Experimental details
- IHC with HSPG2 antibody on frozen human spleen.